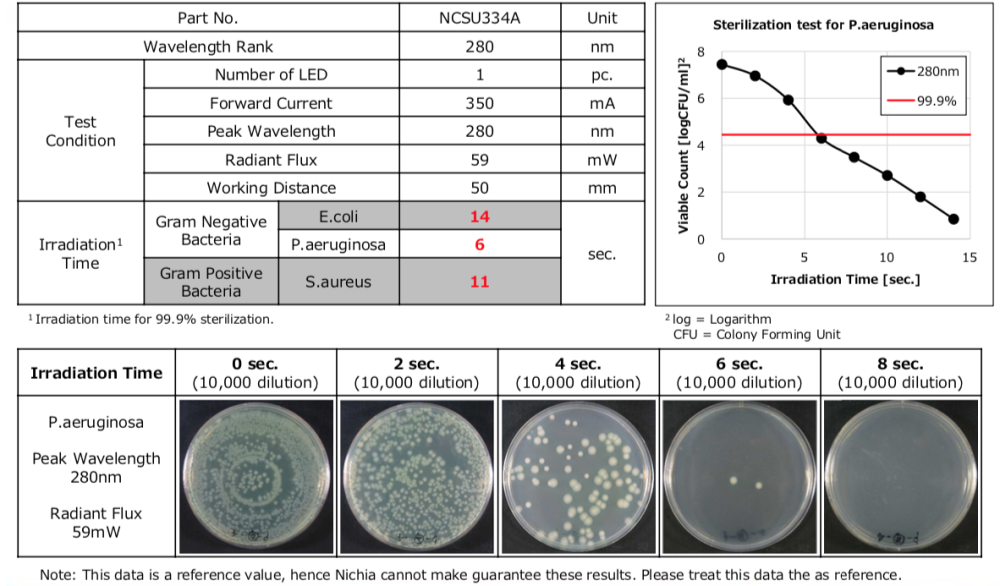
Nichia 280nm Disinfection

Nichia LED NCSU334B UVC 70mW 280nm 1.8W with 30x30mm PCB
- High-performance UV-C LED with 70mW radiant power at 280nm
- PCB version, easy to install with basic soldering iron
- High-quality German-made PCB for best heat transfer and longer LED lifetimes
- Minimal energy consumption of 1.9W
- Ideal for disinfection from viruses and bacteria
- Can achieve a 99% kill rate in less than 20 seconds from a distance of 50mm
- Nichia is the largest LED manufacturer in the world, renowned for inventing the blue and white LED
- Nichia's research department is constantly innovating and setting new efficiency records
- The Nichia brand is known for durability, brightness, and homogeneity, with a fine selection of products for professional processing.
- Buy 25 for €81.90 each and save 6%
The NCSU334B is a top-of-the-line UV-C LED from Nichia, with 70mW of radiant power at a minimal energy consumption of 1.9W. This high-performance LED is ideal for applications in the field of disinfection from viruses and bacteria, and can be used for surface disinfection of objects, with a 99% kill rate achievable in less than 20 seconds from a distance of 50 mm (data for NCSU334A).
Our PCB UVC LED modules make it easy for you to utilize the power of the high-performance Nichia LED in your application without needing a sophisticated soldering station or reflow soldering. The 30x30mm square PCB is manufactured in Germany, ensuring the highest quality and best heat transfer, leading to longer LED lifetimes. Solder pads are easily connected with a basic soldering iron, making the PCB LED ideal for small projects, rapid prototyping, or custom builds.
Nichia is the largest LED manufacturer in the world, known for inventing the blue and white light-emitting diode. Nichia's innovative research department is always pushing the boundaries of efficiency and regularly sets new records. The Nichia brand is known for its durability, brightness, and homogeneity, with a fine selection of products that offer great added value for professional processing.
This performance increases the range of possible applications in the filed of disinfection from viruses and bacteria. One or a small number of Nichia UV-C LEDs can be used for surface disinfection of objects, with 99% kill rate achievable in less than 20 seconds from a distance of 50 mm.
A combination of UVC and UVA LEDs can substantially increase the disinfection capability, as detailed in this article on our blog.
Features
- High performance UV-C NCSU334B SMD LED with 280nm and 70mW typical radiant power on a SQUARE PCB for easy installation
- Typical voltage 5.2V, current 350mA
- Typical power consumption: 1.82W
- 120 deg viewing angle
- Dimensions (LxWxH): 6.8x6.8x2.12mm
Application areas
- Disinfection
- Sterilization
Warning Actinic UV danger for eyes and skin
Ultra violet radiation in the wavelength range of 200-400nm may cause inflammation of the cornea as well as a UV erythema (sunburn) of the skin. The biological effectiveness of the UV radiation varies in the stated wavelength range and is described with the spectral response function (weighting scale) SUV.
See PDF documents for data sheet, safety warning and product guide.
| SKU | 37286 |
|---|---|
| Weight brut (g) | 1.000000 |
| LED Size | 6.8x6.8 mm |
| LED Family | Nichia UV (New!) |
| LED Installation Package | 3x3 cm PCB |
| Color | UVC Ultraviolet |
| Viewing Angle | 120° |
| Forward Current Typ | 350ma |
| Forward Voltage Typ (V) | 5.2 |
| LED Power (W) | 1.82 |
| Wavelength (nm) | 280 |
| Manufacturer Product Code | NCSU334B UV-C |
| Brand | Lumistrips |
| Manufacturer Part Number | NCSU334B UV-C |





























